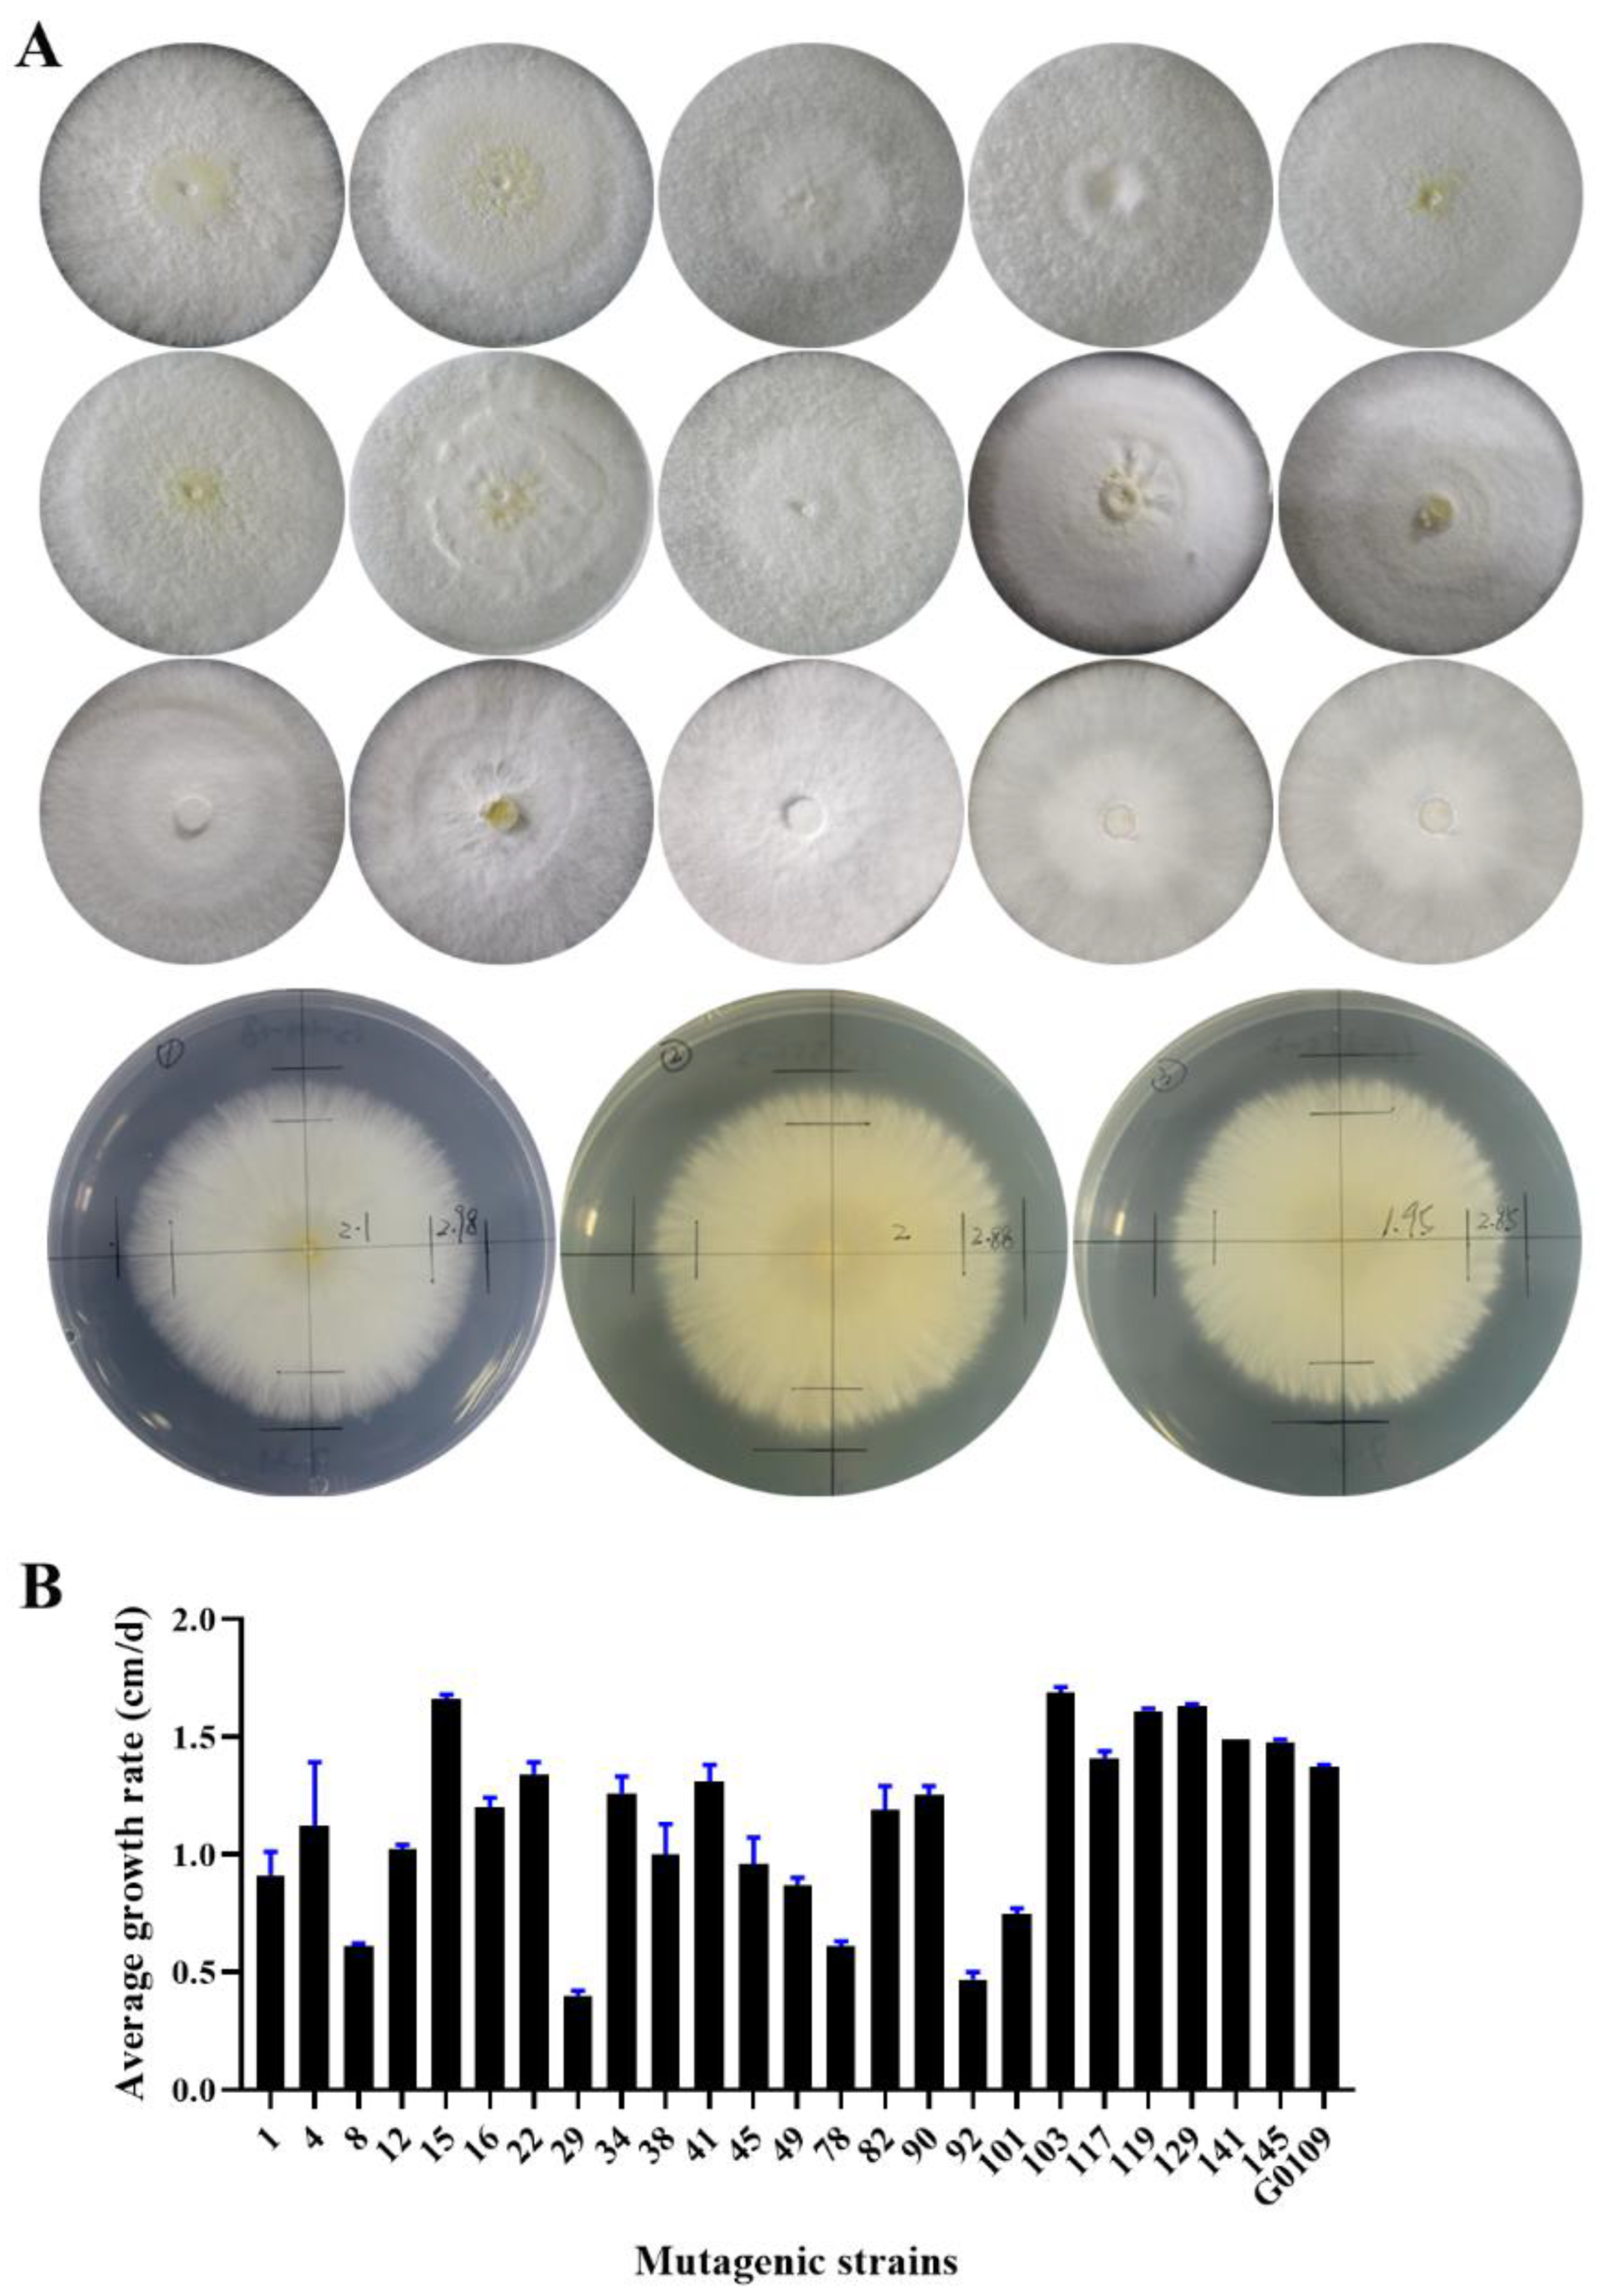
Foods 12 00465 g002
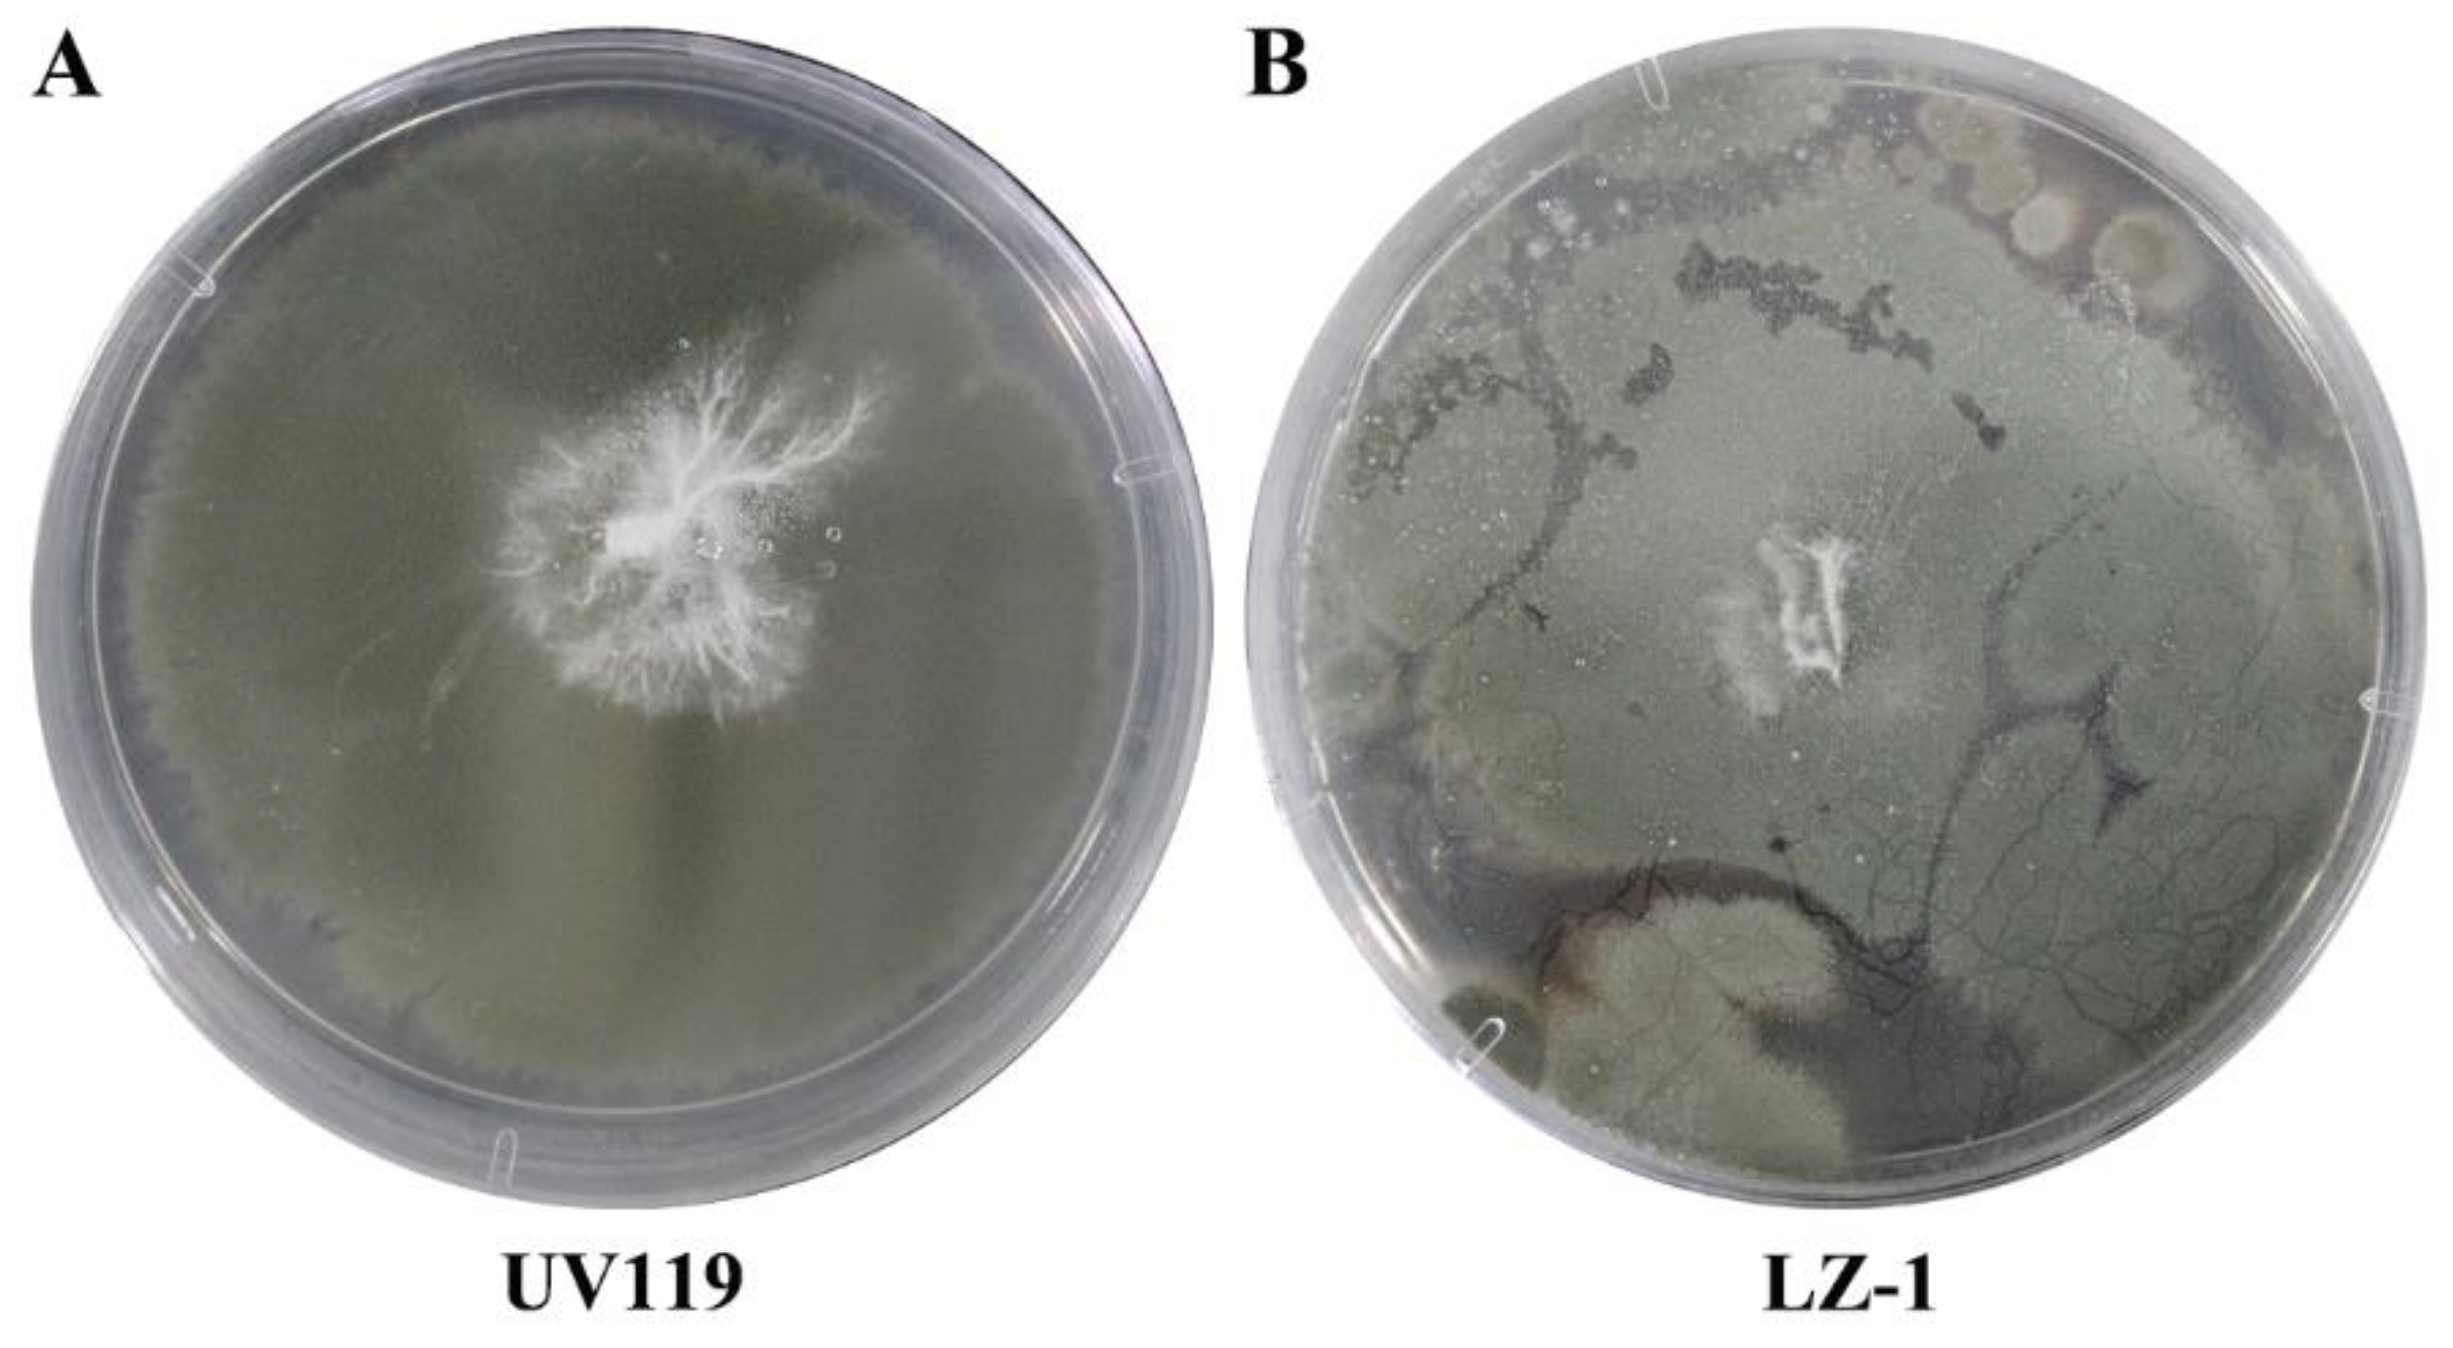
Foods 12 00465 g004

1. Introduction
Ganoderma lucidum (Curtis) P. Karst, called a “top Chinese medicinal material” in
Shennong’s Classic of Meteria Medica, is a treasure of traditional Chinese medicine and has a long history of application in China [
1]. In the last twenty years, many varieties of
G. lucidum with high fruiting body yield and good quality have been bred at home and abroad and made outstanding contributions to the rapid development of the
G. lucidum industry [
2]. In recent years, many studies have found that
G. lucidum spore powder had wide activities and effects, such as antitumor effects and immune modulation, due to its various active ingredients [
3,
4,
5,
6,
7,
8]. Moreover, the content of some major ingredients, such as polysaccharides, is much higher than that of
G. lucidum fruiting bodies [
9,
10].
G. lucidum spore powder products are also edible, convenient and tasty, which makes them more popular with the consumer compared with
G. lucidum fruiting bodies. So far, almost all varieties are only used for the production of
G. lucidum fruiting bodies, and the only variety extensively cultivated to obtain
G. lucidum spore powder is “Longzhi No.1”. However, its poor ability to resist other microbes means it has been gradually abandoned by growers and enterprises, resulting in a dramatic reduction in production. Therefore, more varieties with good resistance to other microorganisms and a high yield of
G. lucidum spores are urgently needed to replace “Longzhi No.1”.
Currently, many fungal breeding strategies such as crossbreeding [
11], protoplast fusion [
12], mutagenesis [
13] and genetically engineered transformation [
14] have been successfully utilized to develop dominant strains in edible and medicinal mushrooms, including
G. lucidum. Crossbreeding was applied to obtain some strains whose polysaccharide and triterpene content was significantly higher than those of the parental strains [
15]. Protoplast fusion of
G. lucidum with a variety of
G. lucidum,
G. sense and other mushroom species, especially those affiliated to different genera of basidiomycetes, has been performed [
16], and various fusions were successfully developed. Qi et al. [
17]. reported that a new strain of
G. lucidum with a distinct mutation was acquired after a space flight. Th genetic transformation of
G. lucidum has also been implemented to express an exogenous glucuronidase gene and the enhanced accumulation of individual ganoderic acids [
18]. At present, the fruiting bodies and spores produced from a new
G. lucidum strain obtained from gene-editing manipulation are prohibited to sold by the Chinese government. Compared with methods such as cross-breeding and protoplast fusion which involve little gene variation, mutagenesis can obtain a large number of mutant strains in a short time, possibly including excellent strains. Artificial mutagenesis using UV irradiation and chemical compounds has been widely conducted to change the basidiospore yield of some mushroom species, including
Pleurotus pulmonarius [
19] and
Pleurotus ostreatus [
20]. In this respect, ultraviolet (UV) ray irradiation may be used to alter the yield of Ganoderma lucidum.
Therefore, considered together, based on a comprehensive comparative analysis of the relevant data from the established germplasm resource information database of G. lucidum, the best G. lucidum strain, G0109, was selected as the original strain to be induced using UV and regenerated; this process could acquire a novel G. lucidum strain with high spore yield and strong resistant ability to undesired microorganisms, which could be used in G. lucidum production.
2. Materials and Methods
2.1. Strains of G. lucidum
G. lucidum strain G0109, as the original strain and current main cultivar “Longzhi No.1”, was preserved in the Edible Fungi Sub-Center of the General Microbiology Culture Collection Center in Shanghai, China. They were maintained in potato dextrose agar (PDA; BD, Sparks, NE, USA) slants at 4 °C.
2.2. Protoplast Mutagenesis and Identification of Mutagenic Strains
G0109 was transferred to a potato dextrose broth medium (PDB; BD, Sparks, NE, USA) for 2 d of shaking culture at 26 °C followed by 6 d of stationary culture at 26 °C. The protoplast of G0109 was prepared with reference to the modified method [
21]. This meant the mycelia were treated at 32 °C for 2.5 h using 2% lywallzyme (Guangdong Institute of Microbiology, Guangzhou, China). A total of 200 μL of protoplast diluted to 10
6/mL was spread onto the regeneration medium plate, and then the plate was wrapped with aluminum-foil paper and cultured at 26 °C in darkness after it was placed 40 cm from a 20 W UV lamp for 50 s. To avoid photoreactivation, irradiation was implemented in darkness. Tiny regeneration colonies after UV ray treatment were transplanted onto a PDA plate to be cultured at 26 °C in darkness. The regeneration strains with dikaryon were confirmed microscopically by the presence of clamp connections on the mycelia. Somatic incompatibilities between dikaryotic strains and the original G0109strain were detected, and the dikaryotic mutagenic strains were determined by the presence of an antagonistic reaction between them and the original strain.
2.3. Mycelia Growth Characteristics of Mutagenic Strains
Mutant strains were firstly activated and then transplanted onto PDA plates with a 5 mm diameter inoculation block to be cultured for 5 days in darkness. The mycelial characteristics of morphology, density and growth rate were observed and measured.
2.4. Evaluation of the Resistance Ability to Other Microorganisms and Fruiting of Mutagenic Strains
For investigation of the capacity of resistance to other microorganisms, the yield ratio of good spawns was analyzed. The spawns were prepared in a polypropylene plastic bag (170 × 350 mm) uniformly packed with 1.0 kg of substrate composed of 78% of sawdust, 13% of wheat bran, 7% of corn powder, 1% of sucrose and 1% of gypsum by dry weight, with water content at 65%. The packed bags were sterilized at 121 °C for 2 h. After cooling to room temperature, the top surface of the substrate was inoculated with mycelial blocks growing on the PDA plates and cultured at 24–26 °C in darkness. They were transferred to a cultivation room in which temperature, moisture and illumination intensity were controllable after 30 days of incubation. The spore yield and fruiting bodies yield were also investigated.
2.5. Evaluation of the Ability of Mutagenic Strains to Resist Trichoderma
The better acquired mutagenic strains and current main cultivar “Longzhi No.1” in the production regions of G. lucidum were cultivated in the same condition. The fruiting body to finished product ratio of their spawn, undesired microorganisms infecting their fruiting bodies, and spore injection in the different growth cycles were investigated to realize the spore yield and resistant ability to undesired microorganisms of the mutagenic strains.
2.6. Stability Test of Mutagenic Strains
The better acquired mutagenic strains were sub-cultured for 15 generations; the fruiting experiments of the 1st, 5th, 10th and 15th generation of the mutagenic strains were conducted under the same conditions. Each strain was inoculated in 500–600 bags of solid substrate, as described in the experiment on the evaluation of resistant ability to other microorganisms and the fruiting of mutagenic strains.
2.7. Statistical Analysis
All data were shown as mean ± standard deviation (SD). Three experiments were performed with at least three replicates each. The student’s t-test was utilized to evaluate the comparisons of two groups, and one-way analysis of variance (ANOVA; SPSS Inc.; Chicago, IL, USA) followed by Tukey’s test was used to assess the differences between multiple groups. Differences were considered to be statistically significant with the p value of less than 0.05.
4. Discussion
Considering that
G. lucidum is a typical tetrapolar heterothallic fungus that has a double factor incompatibility system composed of incompatibility factors A and B [
23], heterokaryons with two different nuclei can produce fruiting bodies and spores. After the induction of
G. lucidum, protoplasts lack cell walls, and regenerated isolates may contain some monokaryons, which cannot fruit. In the present study, new
G. lucidum strains were applied to cultivated ones to obtain
G. lucidum fruiting bodies, especially
G. lucidum spores. To save time and improve the efficiency of screening better strains, observation of the clamp connection structure which only exists in dikaryotic strains was carried out and followed by a somatic incompatibility test, which was employed to identify whether these regenerated dikaryotic strains were mutants different from an original strain at initial screening. Additionally, 213 of 378 regenerated isolates were eliminated, which greatly reduced screening work.
In edible fungi cultivation, dikaryotic strains with fast substrate colonization and growth capacity are usually preferred because a certain positive correlation exists between mycelia growth rate and fruiting body yield [
24]. In this study, in the mutagenesis strains examined, yield did not positively correlate with mycelial growth rate.
A great deal of studies have demonstrated that
G. lucidum exhibits multiple therapeutic activities, including antitumor, antiviral, immune-modulatory, and antihypertensive activities [
25,
26,
27,
28] Additionally, they are becoming more popular and favored among people, with more and more attention being paid to health by society. Therefore, the scale of
G. lucidum cultivation will be expanded dramatically, and the problem of continuous cropping in
G. lucidum cultivation will emerge [
29]. New
G. lucidum strains with the ability to resist other microbes’ invasions are the aim of the breeder. In this study, we attempted to develop an evaluation index to select new strains with the ability to resist undesired microorganisms. Here, we firstly reported that the yield ratio of good spawns was constructed to quickly screen the strains. The good spawn ratio of UV119 is up to 100%, and it also exhibits excellent performance in field cultivation.
Our research for the first time achieved a variety of
G. lucidum with high spore yield and a strong capacity to resist undesired microorganisms, using ultraviolet rays to treat the protoplasts of
G. lucidum. More cultivation cases demonstrated that its fruiting body and basidiospore yields were, respectively, 8.67% and 19.27% higher than those of the original G0109 strain, which proves that it is feasible and effective to obtain a new strain with a high spore yield using ultraviolet rays to induce
G. lucidum strains. The present study is consistent with those research findings demonstrating that ultraviolet irradiation can change the basidiospore yield of
Pleurotus eryngii [
30] and
Coprinus cinereus [
31].
Many mutagenic studies on mycelium and the protoplast of
G. lucidum have been reported, but they were mainly focused on acquiring strains with high biomass, the high content of a certain component or high-activity enzymes for liquid fermentation [
32,
33], although it has also been reported that the varieties “Hunonglingzhi 1”, “Xianzhi 1” and “Longzhi 2”, utilized in solid cultivation for fruiting bodies, were obtained by mutagenesis of the
G. lucidum fruiting body (
Table 7). However, it has not been reported that strains with the agronomic traits of high spore yield of and an ability to resist undesired microorganisms were bred. Based on the database of
G. germplasm resource cultivated in China, which was composed of almost all the strains applied in China, strain G0109, with slightly higher spore yield than other congeneric strains, was selected as the original strain. The protoplasts lacking cell walls were more efficiently mutated by ultraviolet ray treatment and many mutation strains were obtained, which would be a good experimental material used to excavate some genes involved in sporulation and basidiospore yield.
Table 7.
Comparison with recent Ganoderma cultivars.
Table 7.
Comparison with recent Ganoderma cultivars.
| Years | Breeding Methods | Cultivar Name | Characteristics | Ref. |
|---|
| 2013 | UV mutagenesis | Hunonglingzhi 1 | The triterpenes content (16.50 mg/g dry weight fruiting bodies) is 15.83% higher than that of the original strain, and also more resistant to other microbes than the original strain. | [34] |
| 2014 | UV mutagenesis | Xianzhi 1 | Crude polysaccharide content reached up to 24.7 mg/g dry weight of fruiting bodies, which is significantly higher than the original strain | [22] |
| 2014 | Screening from some G. lucidum strains | Longzhi 1 | 1.60 kg basidiospores can be produced per 100 kg of wood substrate | [35] |
| 2016 | Domestication of wild G. lucidum strains | Longzhi 2 | The fruiting bodies almost do not produce basidiospores. | [36] |
| 2016 | Cross breeding using basidiospore-derived monokaryons | H-23 | Its polysaccharide content (16.63 mg/g dry weight fruiting bodies) and triterpene content (10.50 mg/g dry weight fruiting bodies) | [15] |
| 2017 | Space mutation | Xianzhi 2 | 2.12 kg basidiospores can be produced per 100 kg of wood substrate. However, this variety is never widely applied in G. lucidum cultivation. | [37] |
| 2021 | Screening from some wild G. lucidum strains | Xianzhi 3 | Polysaccharide content of basidiospores is 15.30 mg/g dry weight, 22.40% higher than that of Xianzhi 2. | [38] |
In conclusion, an ultraviolet ray irradiation method can be utilized to significantly improve the yield of G. lucidum spores. The UV119 strain was screened and selected according to some indexes, such as mycelial characteristics, resistance ability to other microorganisms, and spore yield. Its mycelia are tiled and dense. Additionally, its mycelial layer is thick, and the good spawn ratio is up to 100% under laboratory conditions. Its fruiting body and basidiospore yields are, respectively, 8.67% and 19.27% higher than those of the original G0109 strain; and the basidiospore yield in particular is 20.56% higher than that of the current main cultivar “Longzhi No.1”. It is worth mentioning that in large-scale field cultivation UV119 shows more excellent performances than the latter, and also exceeds the variety “Xianzhi 2”, bred using space mutation. Therefore, it will be favored and widely applied in the near future.